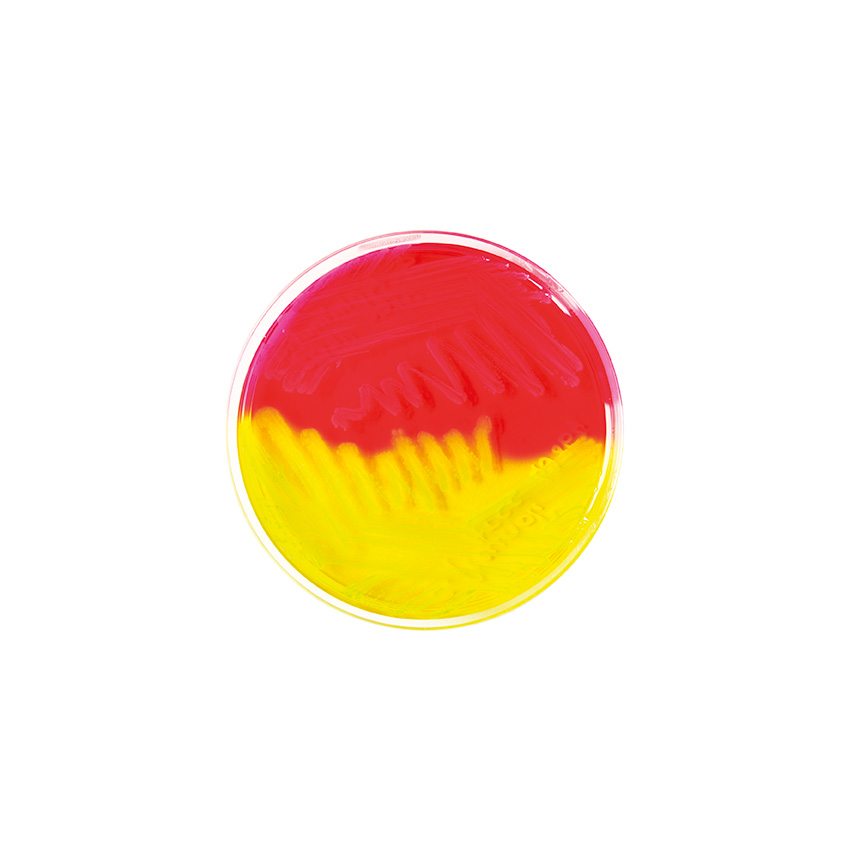

Über das Produkt
MacConkey Agar + Kristallviolett dient der selektiven Isolierung und Differenzierung gram-negativer Enterokokken. Schokoladenagar dient der Isolierung sowie Kultivierung anspruchsvoller Organsimen.
Produkte
Mikrobiologie
Fertigplatten
MacConkey-Agar mit KV / Schokoladen-Agar mit Polyvitex, geteilte Fertigplatten
MacConkey-Agar mit KV / Schokoladen-Agar mit Polyvitex, geteilte Fertigplatten
MacConkey Agar + Kristallviolett dient der selektiven Isolierung und Differenzierung gram-negativer Enterokokken. Schokoladenagar dient der Isolierung sowie Kultivierung anspruchsvoller Organsimen.